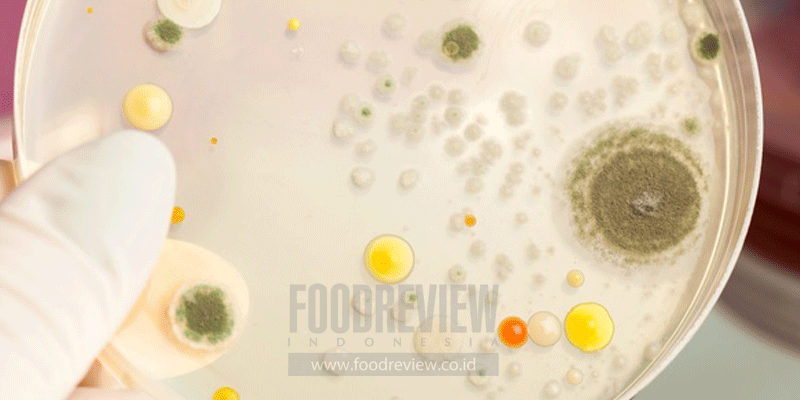

Tuntutan konsumen atas jaminan keamanan pangan membawa dampak bagi bisnis pangan. Pada tahun-tahun terakhir, konsumen telah menyadari bahwa mutu pangan khususnya keamanan pangan paling tidak harus memiliki hasil uji produk akhir di laboratorium yang memenuhi standar. Selain itu, konsumen sudah mulai mengerti bahwa produk dengan mutu yang baik dapat diperoleh dari bahan baku yang baik, ditangani dengan baik, diolah, didistribusikan dengan baik, dan diproses oleh tenaga yang kompeten.
Lebih lengkapnya silakan baca di Foodreview Indonesia edisi Maret 2019: Savor the Flavor. Pembelian & Berlangganan hubungi kami: langganan@foodreview.co.id / 0251 8372 333 / WA 0811 1190 039

